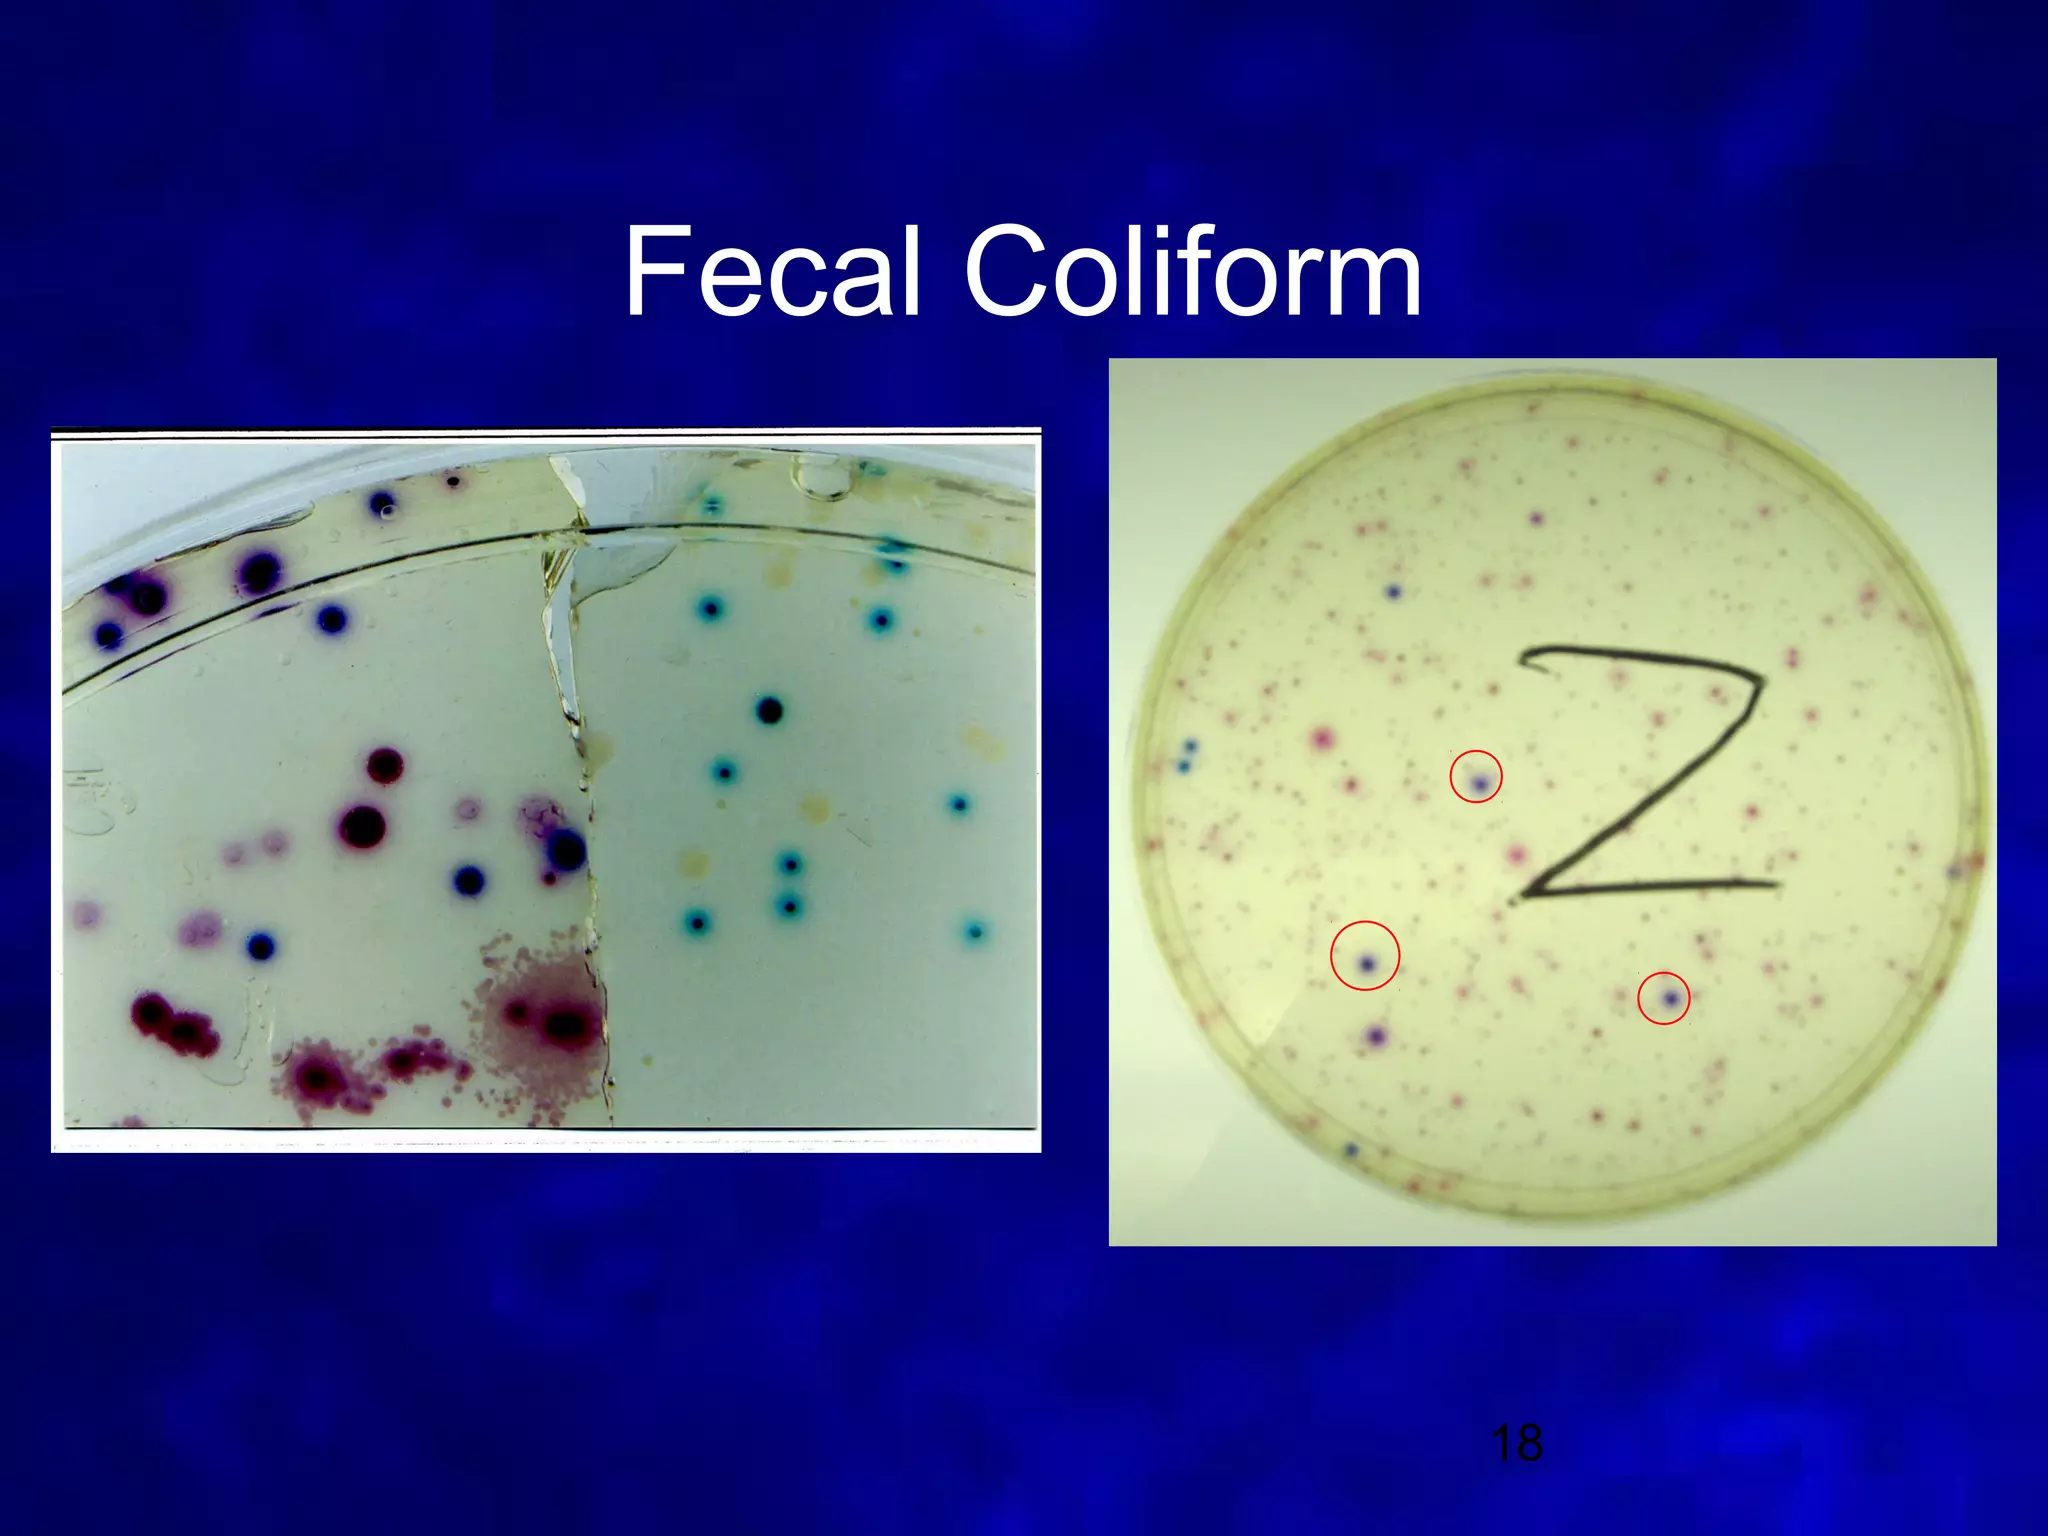
Fecal Coliform




                 18

1. The document summarizes a 2007 watershed study of the Shell Creek and Loseke-Taylor Creek watersheds conducted by researchers from the Lower Platte North Natural Resources District.
2. Water quality tests were performed at 6 sites along the creeks over 4 dates to determine the Water Quality Index (WQI). Tests included dissolved oxygen, fecal coliform, pH, biochemical oxygen demand, temperature, phosphates, nitrates, turbidity, and total solids.
3. Graphs of the test results show variations in water quality measures over time and between sites, with some sites generally having better water quality than others. The study aims to use the WQI and test results to assess and